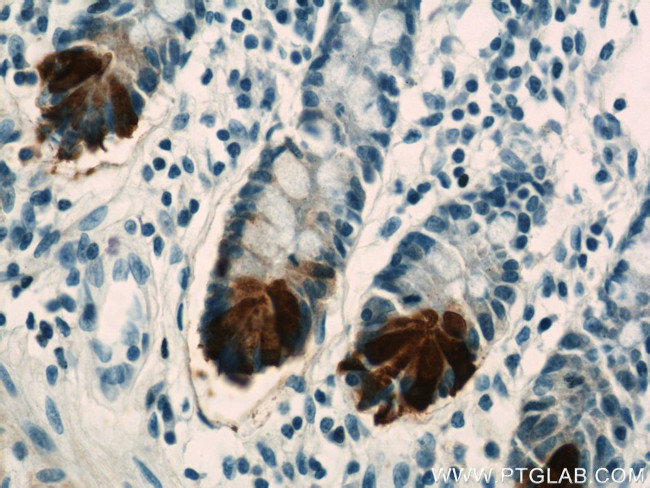
DEFA6 Antibody in Immunohistochemistry (Paraffin) (IHC (P))

Search
Proteintech
DEFA6 Polyclonal Antibody
{{$productOrderCtrl.translations['antibody.pdp.commerceCard.promotion.promotions']}}
{{$productOrderCtrl.translations['antibody.pdp.commerceCard.promotion.viewpromo']}}
{{$productOrderCtrl.translations['antibody.pdp.commerceCard.promotion.promocode']}}: {{promo.promoCode}} {{promo.promoTitle}} {{promo.promoDescription}}. {{$productOrderCtrl.translations['antibody.pdp.commerceCard.promotion.learnmore']}}
产品信息
17923-1-AP
种属反应
宿主/亚型
分类
类型
抗原
偶联物
形式
浓度
规格
纯化类型
保存液
内含物
保存条件
运输条件
产品详细信息
Immunogen sequence: AEPLQAEDD PLQAKAYEAD AQEQRGANDQ DFAVSFAEDA SSSLRALGST RAFTCHCRRS CYSTEYSYGT CTVMGINHRF CCL (19-100 aa encoded by BC093951)
靶标信息
Defensins are a family of microbicidal and cytotoxic peptides thought to be involved in host defense. They are abundant in the granules of neutrophils and also found in the epithelia of mucosal surfaces such as those of the intestine, respiratory tract, urinary tract, and vagina. Members of the defensin family are highly similar in protein sequence and distinguished by a conserved cysteine motif. Several alpha defensin genes appear to be clustered on chromosome 8.
仅用于科研。不用于诊断过程。未经明确授权不得转售。
生物信息学
蛋白别名: Defensin, alpha 6; defensin, alpha 6, Paneth cell-specific; Defensin-6
基因别名: DEF6; DEFA6; HD-6
UniProt ID: (Human) Q01524
Entrez Gene ID: (Human) 1671